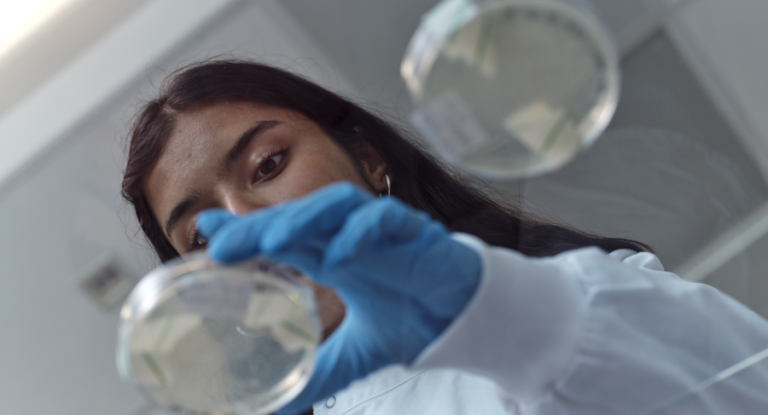

Recognition

Research Recognition
The University of Warwick is a world-leading research-intensive university with the highest academic and research standards. Our ongoing commitment to excellence is reflected our performance in the national frameworks, but also in the drive and passion of our people.
8th
Warwick is ranked 8th University in the UK (The Times and The Sunday Times Good University Guide 2026)
University of the Year (Midlands)
Warwick has won University of the Year in the Midlands (The Times and The Sunday Times Good University Guide 2026)
92%
92% of our research is world-leading or internationally excellent (Research Excellence Framework 2021)
Excellence in Action
We’re proud to be a world-leading research university, where bold ideas and curiosity drive real-world impact. Through academic excellence and industry collaboration, we're working to tackle the most pressing challenges across the globe.

REF 2021 and beyond
The University of Warwick is one of the UK’s academic powerhouses, with 92% of our research assessed to be ‘world leading or internationally excellent’ in REF 2021.
We were also featured in the UK’s top 5 institutions for Economics (2nd), Classics (3rd), Computer Science (4th) and Business and Management (5th).

Knowledge Exchange
Working collaboratively with our business, policy and community partners is at the heart of our purpose.
Find out more about our results in the Knowledge Exchange Framework 2025.

University Rankings
We’re proud to be one of the world’s top universities, ranked 8th in the UK.
In the most recent Teaching Excellence Framework (TEF) Warwick was awarded Gold in all categories: student experience, student outcomes, and overall.

National Centre for Research Culture
Our National Centre for Research Culture works closely with key partners and HEIs nationwide, serving as a long-term hub for knowledge curation, training and innovative research into research culture.
